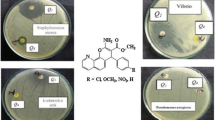

Abstract
The reaction on 8-hydroxy quinoline-7-aldehyde azo compounds (HL n ) (where n = 1–5) with 4-amino-1,2-dihydro-2,3-dimethyl-1-phenylpyrazol-5-one to obtain HL n (where n = 6–10) have been characterized by means of TLC, melting point and spectral data, such as IR, 1H NMR, mass spectra and thermal studies. The X-ray diffraction patterns of two starting materials 8-hydroxy quinoline-7-aldehyde (start 1), 4-amino-1,2-dihydro-2,3-dimethyl-1-phenylpyrazol-5-one (start 2) and the ligands (HL5,10) are investigated in powder form. All the ligands have been screened for their antimicrobial activity against four local bacterial species, two Gram-positive bacteria (Bacillus cereus and Staphylococcus aureus) and two Gram-negative bacteria (Escherichia coli and Klebsiella pneumoniae) as well as against four local fungi; Aspergillus niger, Alternaria alternata, Penicillium italicum and Fusarium oxysporium. The results show that the azo ligands (HL n ) (where n = 1–5) have no antimicrobial activity against bacteria and fungi while most azomethine ligands (HL n ) (where n = 6–10) are good antibacterial agents against E. coli and K. pneumoniae as well as antifungal agents against P. italicum and A. alternata. The results were compared to standard substances (start 1) and (start 2). Among the azomethine ligands, HL10 was the most effective against the most microorganisms tested. The size of clear zone was ordered as p-(OCH3 < CH3 < H < Cl < NO2) as expected from Hammett’s constant (σ R). Also, the ultrastructure study of the affected bacteria confirmed that HL8 is good antibacterial agent against E. coli and S. aureus.
Similar content being viewed by others
Avoid common mistakes on your manuscript.
Introduction
Azo dyes constitute one of the largest and most varied groups of synthetic organic dyes in use today [1]. The major classes of dyes have anthroquinoid, indigoid and azo aromatic compounds. The chemical structure of azo dyes is comprised of a conjugated system of double bonds and aromatic rings. All these structures allow strong π–π* transitions in the UV–visible (UV–Vis) area, with high extinction coefficients. The drawback of these dyes is that they are not easily degraded by aerobic bacteria, and with the action of anaerobic or microaerobic reductive bacteria, they can form toxic or mutagenic compounds such as aromatic amines [2–4].
In addition, Schiff bases are some of the most widely used organic compounds. They are used as pigments and dyes, catalysts, intermediates in organic synthesis and as polymer stabilizers [5]. Schiff bases have also been shown to exhibit a broad range of biological activities, including antifungal, antibacterial, antimalarial, antiproliferative, anti-inflammatory, antiviral and antipyretic properties [5–8]. It has been suggested that azomethine linkage (C=N) might be responsible for the biological activities of Schiff bases [9].
Because of excellent yield and fast reaction, many researchers have developed azo Schiff base compounds and studied their properties and different applications [10, 11].
The quinoline nucleus has gathered immense attention among chemists as well as biologists as it is one of the key building elements for many naturally occurring compounds [12], while 8-hydroxyquinolines have been explored as a viable drug discovery platform in many instances. They can exert their physiological properties through bidentate chelation of metal ions [13].
Different quinoline compounds have been tested against fungi, a range of Gram-positive and Gram-negative bacteria, including Staphylococcus aureus and Escherichia coli [14–16]. Lam et al. [14] synthesized and characterized various derivatives of 8-hydroxyquinoline and studied their potential antibacterial activity against Gram-positive S. aureus and Gram-negative E. coli. They found that these quinoline compounds had no effect on E. coli, while showing antibacterial effect against S. aureus. They found that the synthetic 5,7-dibromo-2-methylquinolin-8-ol derivative shows a similar minimum inhibitory concentration (MIC) of 6.25 µg/mL as compared to that of methicillin (3.125 µg/mL) against Staphylococcus aureus. El-Behery et al. [15] synthesized a Schiff base hydrazone derived from 7-chloro-4-hydrazinoquinoline and its complexes with Cu(II), Ni(II), Co(II), Fe(III), and UO2(II) ions. Also, they tested the Schiff base ligand and its metal complexes against one stain Gram-positive bacteria (S. aureus), Gram-negative bacteria (E. coli), and yeast (Candida albicans) and they found that, their compounds exhibited higher antibacterial acivities. Abou-Dobara et al. [16] studied the antimicrobial activity of azodye ligands) and their complexes [Cu(II)/Ni(II)] against four local bacterial and fungal species. They reported that these azodye compounds have good antibacterial activity against B. cereus, E. coli and K. pneumoniae, the complexes were being more toxic than ligands against fungi and Cu2+ complexes were being more active than Ni2+ complexes against B. cereus, E. coli and K. pneumoniae.
In view of the facts mentioned above, a new series of azo Schiff bases of 8-hydroxyquinoline-7-aldehyde azodye ligands with 4-amino-1,2-dihydro-2,3-dimethyl-1-phenylpyrazol-5-one were synthesized and have been evaluated for their antimicrobial activity. Azodye ligands of 8-hydroxyquinoline-7-aldehyde and its derivatives have been prepared and characterized by elemental analyses, 1H-NMR and IR spectra [17].
The aim of the present work is to synthesize 4-{[5-(4-substituted-phenylazo)-8-hydroxy-quinolin-7-ylmethylene]-amino}-1,5-dimethyl-2-phenyl-1,2-dihydropyrazol-3-one derivatives (HL n ) (where n = 6–10), and then test the antimicrobial activity of the HL(1–10) ligands against two Gram-positive and two Gram-negative bacteria in addition to four different types of fungi. The effect of HL8 on the ultrastructure of two affected bacteria is also investigated.
Experimental
Materials
4-Amino-1,2-dihydro-2,3-dimethyl-1-phenylpyrazol-5-one and various aniline or p-substituted anilines were purchased from Aldrich, and the other chemicals were of analytical grade quality.
Preparation of (5-(4′-derivatives phenyldiazo)-8-hydroxy-7-quinolinecarboxaldehyde) (HL1–5)
8-Hydroxy-7-quinolinecarboxaldehyde was prepared according to El-Sonbati and El-Bindary [18]. (5-(4′-derivatives phenylazo)-8-hydroxy-7-quinolinecarboxaldehyde) HL n where (n = 1–5) prepared according to El-Sonbati et al. [17, 19] (Table 1). Azo dye ligands (HL n ) were prepared from aniline or its p-substituted derivatives (10 mmol) dissolved in hydrochloric acid (20 mmol/25 ml distilled H2O). The hydrochloric compound was diazotized below 0–5 °C with a solution of sodium nitrite (0.8 g, 10 mmol, 30 ml distilled H2O). The diazonium chloride was coupled with an alkaline solution of oxine (1.7 g, 10 mmol) in 20 ml of pyridine. The crude dye was collected by filtration and was crystallized from DMF, then dried in a vacuum desiccator over P2O5. The preparation of (HL1–5) is summarized in Fig. 1.
Preparation of 4-{[5-(4-methoxy-phenylazo)-8-hydroxy-quinolin-7-ylmethylene]-amino}-1,5-dimethyl-2-phenyl-1,2-dihydro-pyrazol-3-one (HL6–10)
Ethanolic solutions of 4-amino-1,2-dihydro-2,3-dimethyl-1-phenylpyrazol-5-one (0.1 mol) and [5-(4′-derivatives phenyldiazo)-8-hydroxy-7-quinolinecarboxaldehyde)] (HL1–HL5) (0.1 mol) were refluxed for 4 h over a steam bath. The excess solvent was removed by evaporation and the concentrated solution was cooled in an ice bath with stirring. The azo Schiff base (HL n ) separated out as a colored powder and was recrystallized from ethanol, then dried in a vacuum desiccator over P2O5. The purity of the ligands was checked by TLC. Our synthetic route of azo Schiff base ligands is shown in Scheme 1. The color, yield % and analytical data are given in Table 2.
The resulting formed ligands are:
-
(5-(4′-methoxyphenylazo)-8-hydroxy-7-quinolinecarboxaldehyde) (HL1)
-
(5-(4′-methyl phenylazo)-8-hydroxy-7-quinolinecarboxaldehyde) (HL2)
-
(5-(4′-phenylazo)-8-hydroxy-7-quinolinecarboxaldehyde) (HL3)
-
(5-(4′-chlorophenylazo)-8-hydroxy-7-quinolinecarboxaldehyde) (HL4)
-
(5-(4′-nitrophenylazo)-8-hydroxy-7-quinolinecarboxaldehyde) (HL5)
-
4-{[5-(4-methoxy-phenylazo)-8-hydroxy-quinolin-7-ylmethylene]-amino}-1,5-dimethyl-2-phenyl-1,2-dihydro-pyrazol-3-one (HL6)
-
4-{[5-(4-methyl-phenylazo)-8-hydroxy-quinolin-7-ylmethylene]-amino}-1,5-dimethyl-2-phenyl-1,2-dihydro-pyrazol-3-one (HL7)
-
4-{[5-(4-phenylazo)-8-hydroxy-quinolin-7-ylmethylene]-amino}-1,5-dimethyl-2-phenyl-1,2-dihydro-pyrazol-3-one (HL8)
-
4-{[5-(4-chlorophenylazo)-8-hydroxy-quinolin-7-ylmethylene]-amino}-1,5-dimethyl-2-phenyl-1,2-dihydro-pyrazol-3-one (HL9)
-
4-{[5-(4-nitrophenylazo)-8-hydroxy-quinolin-7-ylmethylene]-amino}-1,5-dimethyl-2-phenyl-1,2-dihydro-pyrazol-3-one (HL10).
Microbiological investigation
For this investigation, the agar well diffusion method was applied [20]. The antibacterial activities of the investigated compounds were tested against two local Gram-positive bacteria (B. cereus and S. aureus) and two local Gram-negative bacteria (E. coli and K. pneumoniae) on nutrient agar medium. Also, the antifungal effect was tested against four local fungal species (Aspergillus niger, Alternaria alternata, Penicillium italicum and Fusarium oxysporium) on DOX agar medium. The concentrations of each solution were 50, 100 and 150 µg/mL. By using a sterile cork borer (10 mm diameter), wells were made in agar medium plates previously seeded with the test microorganism. Then, 200 µl of each compound was applied in each well. The agar plates were kept at 4 °C for at least 30 min to allow the diffusion of the compound, then incubated at 30 °C or 37 °C for bacteria and fungi, respectively. Penicillin and miconazole were used as antibacterial and antifungal substrates, respectively. The diameters of inhibition zones were determined after 24 h for bacteria and after 7 days for fungi. For electron microscopic study, overnight cultures of E. coli and S. aureus were subjected to 150 µg/mL of HL8 for 2 h. Non-treated (control) bacteria and DMF-treated bacteria were also included. After that, bacterial cells were centrifuged and washed with distilled water. The bacteria were fixed with formalin-glutaraldehyde fixative (4F1G) in 0.1 M phosphate buffer pH 7.4. After rinsing in the buffer, samples were post-fixed in 2 % OsO4 for 2 h at 4 °C in the same buffer. The cells were washed and dehydrated at 4 °C through a graded series of ethanol. Cells were then treated with propylene oxide solution and embedded in a mixture of 1:1 of Epon-Araldite for 1 h. Polymerization was done in the oven at 65 °C for 24 h. Ultrathin sections (50 μm) were cut on an ultratome (Model LKB), then mounted on copper grids, double-stained with uranyl acetate and lead citrate and investigated on a JEOL 100CX (TEM).
Measurements
Elemental microanalyses of the separated ligands chelates for C, H and N were performed in the Microanalytical Center at Cairo University, Egypt. The analyses were repeated twice to check the accuracy of the analyzed data. Melting or decomposition points were carried out on a melting point apparatus. The 1H-NMR spectrum was obtained with a JEOL FX90 Fourier transform spectrometer with DMSO-d6 as the solvent and TMS as an internal reference. Infrared spectra were recorded as KBr pellets using a Pye Unicam SP 2000 spectrophotometer. Ultraviolet–visible (UV–Vis) spectra of the compounds were recorded in Nujol mulls using a Unicom SP 8800 spectrophotometer. X-ray diffraction patterns of the powder forms were recorded on X-ray diffractometer (Philips x’pert) with Ni-filtered CuKα-radiation (λ = 1.5418 Å) in the range of diffraction angle (2θ° = 4°–70°). The applied voltage and the tube current are 30 kV and 30 mA, respectively. Mass spectra were recorded by the EI technique at 70 eV using MS-5988 GS-MS Hewlett-Packard. Thermal studies were computed on Simultaneous Thermal Analyzer (STA) 6000 system using thermogravimetric analysis (TGA) method. Thermal properties of the samples were analyzed in the temperature range from 30 to 800 °C at the heating rate of 10 °C/min under dynamic nitrogen atmosphere.
Morphometric analysis
Morphometric analyses were achieved by using UTHSCSA Image tool software for Wndows v.3.
Statistical analysis
All the data of morphometric analysis are expressed as mean ± SE. The statistical significance was evaluated by ANOVA using SPSS v.10 and the individual comparisons were obtained by the LSD method at 0.05 significance levels.
Results and discussion
Characterization of azo dye ligands HL n (n = 1–5)
The structure of [5-(4′-derivatives phenylazo)-8-hydroxy-7-quinolinecarboxaldehyde] HL n where (n = 1–5) using various physico-chemical properties like color, yield and elemental analysis which are given in Table 1. The elemental analytical data of ligands agreed well with the calculated values as shown in Fig. 1.
The 1H NMR spectra of quinolone and its alkyl derivatives found two signals in the ~9.10–12.43 and ~8.89–9.28 ppm regions assigned to δ(OH) and δ(CN), respectively. 1H NMR studies for the free ligands under investigation in DMSO-d6 also show two signals at δ 9.3–9.7 and 8.95–9.3 ppm which are similar to those observed previously [21–24]. Those signals are also assigned to the protons of OH and CN, respectively, in the spectra of the free ligands under investigation. The –OH proton signals exhibit fast exchange in the presence of D2O, i.e., it disappeared in the presence of D2O and this is attributed to the strongly hydrogen bonding as in Fig. 1. The shifts are in the sequence: p-NO2 > p-Cl > H > p-CH3 > p-OCH3. In the 13C NMR spectra, there is no detectable signal for the carbon of carbonyl group (C=O) at the quinoline ring for the hydrazone form. Also, two broad bands (OH signals) were determined from the azo form of ligands in the 1H NMR spectrum. The signal for the N–H proton of ligands for the hydrazone form was not observed in DMSO-d6. The singlet peaks at 56.32 ppm are due to the methoxy (OCH3) carbons. The aromatic carbons (C=C), hydroxyl rings and aldehydic group are observed in the extensive 111.5–153.2 ppm range.
The electronic spectra of HL n ligands exhibited bands at 32,500–32,150 cm−1 (CN) (π–π*), 33,450–33,340 cm−1 (H-bonding and association), 40,038–39,460 cm−1 (phenyl) (Ph–Ph*, π–π*) [20] and 29,340–29,230 cm−1 transition of phenyl rings overlapped by composite broad (π–π*) of the azo structure. The band due to the n → π* transition obtained in the visible region is associated mainly with the color of the respective compound [23]. The analytical data and the spectral properties of the ligands are consistent with their structure in Fig. 1.
Characterization of azo Schiff base ligands HL n (n = 6–10)
The ligands (HL6–10) were prepared by stirring an appropriate amount of reactive p-derivatives 8-hydroxy quinoline-7-aldehyde (azo compounds) with the corresponding 4-amino-1,2-dihydro-2,3-dimethyl-1-phenylpyrazol-5-one in ethanol. The formed Schiff base azo ligands (HL6–10) were characterized with respect to their composition by elemental and spectral analysis. All five ligands HL6–10, gave satisfactory elemental analyses (Table 2). Detailed solution and solid state studies of these ligands were carried out to establish their geometry.
As shown in Table 2, the values of yield % is related to the nature of the p-substituent as they increase according to the following order p-(NO2 > Cl > H > CH3 > OCH3). This can be attributed to the fact that the effective charge experienced by the d-electrons increased due to the electron-withdrawing p-substituent (HL9 and HL10) while it decreased with the electron-donating character of (HL6 and HL7). This is in accordance with that expected from Hammett’s substitution coefficients (σR), as in Fig. 2 the yield % values correlate with (σR), and it is clear that all these values increase with increasing σR [22–26].
X-ray diffraction analysis
The X-ray diffraction patterns (XRD) of 8-hydroxy quinoline-7-aldehyde (start 1), 4-amino-1,2-dihydro-2,3-dimethyl-1-phenylpyrazol-5-one (start 2) and the ligands (HL5 and HL10) in powder form are shown in Figs. 3 and 4, respectively. Broad peaks for start 1 at 2θ = 16° and 23° indicating an amorphous structure (Fig. 3a). Many peaks are observed which indicate the polycrystalline nature of start 2 (Fig. 3b). According to Fig. 4, the XRD patterns of (HL5 and HL10) show that the peak appeared at 2θ = 16° for HL5 is a mixture of amorphous and polycrystalline structures (Fig. 4a), while HL10 is completely amorphous with two peaks appearing at 2θ = 24° and 45° (Fig. 4b).
Mass spectra
The electron impact mass spectrum of HL2, HL6, HL8 and HL9 ligands were recorded and investigated at 70 eV of electron energy. For HL2, It is obvious that the molecular ion peaks are in good agreement with their suggested empirical formulae as indicated from the elemental analysis (Table 1). The mass spectrum fragmentation mode of ligand (HL2) shows the exact mass of 291 corresponding to the formula C17H13N3O2 (Fig. 5). The ion of m/z = 291 undergoes fragmentation to a stable peak at m/z = 263 by losing C=O atoms (structure I) as shown in Scheme 2. The loss of CHO leads to the fragmentation with m/z = 234 (structure II). The loss of C5H5 atoms leads to the fragmentation with m/z = 169 (structure III). The loss of C2H2 atoms leads to the fragmentation with m/z = 143 (structure IV). A breakdown of the backbone of HL2 ligand gives the fragments (V) and (VI).
It is obvious that the molecular ion peaks for ligands (HL6, HL8 and HL9) are in good agreement with their suggested empirical formula as indicated from the elemental analysis (Table 2). The mass spectrum fragmentation mode of ligand (HL6) shows the exact mass of 493 corresponding to the formula C28H25N6O3 (Fig. 6a). The ion of m/z = 493 undergoes fragmentation to a stable peak at m/z = 279 by losing C12H12N3O atoms (structure I) as shown in Scheme 3a. The loss of C6H7O leads to the fragmentation with m/z = 185 (structure II). The loss of C3H5 atoms leads to the fragmentation with m/z = 142 (structure III). A breakdown of the backbone of HL6 ligand gives the fragments (IV) and (V).
The mass spectrum fragmentation mode of ligand (HL8) shows the exact mass of 462 corresponding to the formula C27H22N6O2 (Fig. 6b). The ion of m/z = 462 undergoes fragmentation to a stable peak at m/z = 249 by losing C12H12N3O atoms (structure I) as shown in Scheme 3b. The loss of C6H5N2 leads to the fragmentation with m/z = 144 (structure II). A breakdown of the backbone of HL8 ligand gives the fragments (III) and (IV).
The mass spectrum fragmentation mode of ligand (HL9) shows the exact mass of 496.5 corresponding to the formula C27H21N6O2 Cl (Fig. 6c). The ion of m/z = 496.5 undergoes fragmentation to a stable peak at m/z = 445 by losing C4H4 atoms (structure I) as shown in Scheme 3c. The loss of C7H5N3O leads to the fragmentation with m/z = 299 (structure II). The loss of CH3 atoms leads to the fragmentation with m/z = 283 (structure III). The loss of C6H5N2Cl atoms leads to the fragmentation with m/z = 144 (structure IV). A breakdown of the backbone of HL9 ligand gives the fragments (V) and (VI).
Thermogravimetric analysis
The TGA curves of azo (HL1–5) and azo Schiff base ligands (HL6–10) are shown in Fig. 7(a and b), respectively. It is clear from these figures that the change of azo group to azomethine strongly affects the decomposition behavior. The detailed analysis of the behavior of decomposition for both azo (HL1–5) and azo Schiff base (HL6–10) ligands are presented in Tables 3 and 4, respectively. For azo ligands HL1–5, the TGA curves shown in Fig. 7a reveal that the decomposition process starts at a temperature in the range 150–200 °C depending on the function group, while in the first stage of heating, HL1 (p-OCH3) losses about 4.873 % of its weight, this loss can be attributed to the loss of moisture adsorbed in the matrix [22]. TGA curves of azo Schiff base ligands HL6–10 shows three steps of decomposition as shown in Fig. 7b. The decomposition process starts at temperature in the range 35–240 °C depending on the function group.
More results about the degradation process can be extracted from the TGA curves as follow. The rate constant of the thermal degradation (K) is given by the Arrhenius relationship [22]:
where R is a gas constant (=8.314 JK−1 mol−1) and E d the thermal activation energy of decomposition. The values of E d for HL1–5 azo ligands and azo Schiff base ligands HL6–10 can be obtained by plotting ln K as a function of 1/T. The values of E d of HL n (=−R.slope) are found to be in the range (22.92–143.28) for HL1–5 and in the range (18.6–51.8) for HL6–10, respectively, as shown in Table 5. The high values of E d for HL1–5 than HL6–10 indicate that the azo ligands are more stable than the Schiff base ligands.
Calculation of activation thermodynamic parameters
The thermodynamic activation parameters of decomposition processes of the azo (HL1–5) and azo Schiff base ligands (HL6–10), namely activation energy (E a), enthalpy (ΔH*), entropy (ΔS*), and Gibbs free energy change of the decomposition (ΔG*), are evaluated graphically by employing the Coast–Redfern [27] and Horowitz–Metzger [28] methods.
Coast–Redfern equation
The Coast–Redfern equation, which is a typical integral method, can be represented as:
For the convenience of integration, the lower limit T 1 is usually taken as zero. This equation on integration gives:
A plot of the left-hand side (LHS) against 1/T was drawn for the azo ligands (HL1–5) and azo Schiff base ligands (HL6–10) in Fig. 8a and b, respectively. E a is the energy of activation in J mol−1 and calculated from the slope and A in (s−1) from the intercept value. The entropy of activation (ΔS*) in (J mol−1 K−1) was calculated by using the equation:
where k B is the Boltzmann constant, h is the Plank’s constant and T s is the TG peak temperature.
Horowitz–Metzger equation
The Horowitz–Metzger equation is illustrative of the approximation methods. These authors derived the relationship:
when n = 1, the LHS of Eq. (4) would be log[−log(1 − α)] as shown in Fig. 9a and b, respectively, for (HL1–5) and (HL6–10). For a first-order kinetic process, the Horowitz–Metzger equation may be written in the form:
where θ = T − Ts, w γ = w α − w, w α = mass loss at the completion reaction; w = mass loss up to time t. The plot of log [log (w α/w γ)] versus θ was drawn and found to be linear from the slope from which E a was calculated. The pre-exponential factor, A, calculated from equation:
The entropy of activation, ΔS*, is calculated from Eq. (3). The enthalpy activation, ΔH *, and Gibbs free energy, ΔG*, are calculated from:
The calculated values of E a, A, ΔS *, ΔH * and ΔG* for the decomposition steps for azo ligands (HL1–5) and azo Schiff base ligands (HL6–10) are summarized in Table 6. The entropy of activation energies reflects the thermal stability of the compounds. The entropy of activation is found to have negative values in the HL n (where n = 1–10), which indicate that the decomposition reactions proceed spontaneously [29, 30]. The value of ΔG * is positive, considered as a favorable or spontaneous reaction.
From the values of the energy of activation (E a) of all the ligands (HL1–10), it is observed that the azo ligands (HL1–5) are more stable than the azo Schiff base ligands (HL6–10).
Microbiological investigation
The Gram-negative rods have been implicated in infections as diverse as pneumonia to ear infections. One of the more common Gram-negative rods that cause disease in humans is E. coli. According to Bailey and Scott’s “Diagnostic Microbiology,” E. coli is by far the most common cause of uncomplicated community-acquired urinary tract infections and is frequently seen in wound infections. Certain strains of E. coli (such as E. coli O157:H7) can cause serious diarrhea and kidney damage [31, 32].
The antimicrobial activity of HL n (where n = 1–10) ligands were tested against bacteria and fungi; we used more than one test organism to increase the chance of detecting their antimicrobial activities. The used organisms in the present investigations included two Gram-positive bacteria (B. cereus and S. aureus) and two Gram-negative bacteria (E. coli and K. pneumoniae) in addition to four species of fungi; (A. niger, P. italicum, A. alternata and F. oxysporium).
None of the used azo ligands (HL n ) (where n = 1–5) were found to have any antibacterial activity. However, the used azo Schiff base ligands (HL n ) (where n = 6–10) were found to have antibacterial activity. The results of the antibacterial activities of the synthesized azo Schiff base ligands (HL6–10) are recorded in Table 7.
According to Table 7, HL6–10 have antibacterial activity against E. coli (inhibition zone of HL6 = 2 and 3 mm at concentrations = 50 and 100 µg/mL, respectively), (inhibition zone of HL7 = 2 mm at concentrations = 50 and 100 µg/mL and = 3 mm at concentration = 150 µg/mL), (inhibition zone of HL8 = 3 mm at concentrations = 100 and 150 µg/mL), (inhibition zone of HL9 = 2 mm at concentrations = 50, 100 and 150 µg/mL) and (inhibition zone of HL10 = 3 mm at concentrations = 50 and 100 µg/mL and = 4 mm at concentration = 150 µg/mL). Addition to that K. pneumoniae was also weekly affected by HL6–10 (inhibition zone of HL6 = 1 mm and HL9 = 2 mm at concentration = 150 µg/mL), (inhibition zone of HL7 = 2 mm and = 1 mm at concentrations = 100 and 150 µg/mL, respectively) and (inhibition zone of HL10 = 1 mm at concentrations = 50, 100 and 150 µg/mL, respectively) as shown in Fig. 10. HL6–10 ligands were found to have antibacterial activity against E. coli than against K. pneumoniae, and HL10 has high activity more than other ligands as shown in Figs. 11 and 12. HL10 is more active than penicillin against E. coli and K. pneumoniae, whereas the HL n and their derivatives have no effect against Gram-positive bacteria.
As shown in Table 7, the values of inhibition zones for ligands (HL6–10) are related to the nature of the p-substituent as they increase according to the following order: p-(NO2 > Cl > H > CH3 > OCH3) [25]. This can be attributed to the fact that the effective charge experienced by the d-electrons increased due to the electron-withdrawing p-substituent (HL9 and HL10) while it decreased by the electron-donating character of (HL6 and HL7). This is in accordance with that expected from Hammett’s substitution coefficients (σ R) as shown in Fig. 13a, b. Correlating the values of inhibition zone (mm) with σ R, it is clear that these values increase with increasing σ R. It is important to note that the existence of a methyl and/or methoxy group enhances the electron density on the coordination sites and simultaneously decreases the values of inhibition zone.
The results in Table 7 reveal that the azo Schiff base ligands are moderately toxic against Gram-positive bacteria. Both ligands (HL6–10) are more active against E. coli and K. pneumoniae.
Patel [33] found that 5-(4-N,N-diethylaminosulfonly phenylazo)-8-hydroxy quinoline and their metal chelates have moderate and high toxicity against some fungi including Aspergillus niger and Penicillium expansum. Our results of the antifungal activities of the azo Schiff base ligands (HL6–10) are recorded in Table 8. The results of the examination of antifungal activity of HL6–10 ligands revealed that the ligands have moderate toxicity against fungi.
The values of inhibition zone for ligands (HL6–10) are shown in Table 8, HL6–10 have antifungal activity against A. alternata (inhibition zone of HL6 = 5 mm at concentration = 100 µg/mL), (inhibition zone of HL7 and HL9 = 7 mm at concentration = 150 µg/mL) and (inhibition zone of HL10 = 7 mm at concentrations = 100 and 150 µg/mL) as shown in Table 8 and Fig. 14. In addition to that P. italicum was also affected by HL n (inhibition zone of HL6 = 4 and 2 mm at concentrations = 50 and 100 µg/mL, respectively), (inhibition zone of HL7 = 5 mm at concentration = 50 µg/mL and = 1 mm at concentrations = 100 and 150 µg/mL), (inhibition zone of HL8 = 5 and 3 mm at concentrations = 50 and 100 µg/mL, respectively), (inhibition zone of HL9 = 1 mm at concentrations = 50 and 150 µg/mL) and (inhibition zone of HL10 = 3, 2 and 1 mm at concentrations = 50, 100 and 150 µg/mL, respectively). HL6–10 have low antifungal activity against F. oxysporum (inhibition zone of HL7 and HL10 = 1 mm at concentration = 100 µg/mL) and (inhibition zone of HL8 and HL9 = 3 mm at concentrations = 150 and 100 µg/mL, respectively).
The results of the TEM comparative study on the morphology and internal ultrastuctures; of normal and HL8-treated E. coli and S. aureus provided strong evidence that HL8 is stressful and toxic for the bacterial cells. In general, treatment of E. coli with HL8 resulted in significant morphometric changes, whilst similar exposure of S. aureus produced no significant morphometric changes (Table 9). However, HL8 prevents S. aureus’ ability to adapt by reducing size, as shown in Fig. 15, and thickening the cell walls was seen with DMF treatment (Table 9). In the case of DMF treatment, S. aureus could resist the stressful conditions and keep its cell structure by thickening the cell walls and accelerating its cell division (Fig. 16). On the other hand, HL8-treated S. aureus cell walls then appear electron lucent and damaged in some cells (Fig. 17). Internal cell components of S. aureus in the case of DMF are kept stable although some electron dense granules appear in the cytoplasm (Fig. 16), whereas HL8 treatment leads to S. aureus cell damaged at all in different stages. These stages include electron dense granules and electron lucent vacuoles formation in the cytoplasm, weakening and damaging of the boundary cell wall and finally granular cell contents exudes from the damaged membrane. The E. coli, DMF treatment did not result in any significant cytomorphological changes (Figs. 18, 19), whereas HL8 treatment was found to significantly reduce the width of the E. coli cells (Table 9) resulting in malformed cells (Fig. 20). Furthermore, the main effect of HL8 begins in the cytoplasm by vacuolation then damages the cell wall (Fig. 20) without affecting the distance between the cell wall and the cell membrane (Table 9). TEM examination of HL8-treated E. coli and S. aureus confirmed that HL8 has a bactericidal effect against both bacteria, as granular cell contents appear to exude from the damaged cell membrane (Figs. 17, 20) [34–37].
Transmission electron micrograph of normal S. aureus illustrating different size of cocci cells, normal thin electron dense cell walls, homogenous electron dense cytoplasm, normal division and numerous ribosomes (asterisks). (Specimen fixed in 4F1G solution and double-stained with uranyl acetate and lead citrate; original magnification ×7500)
Transmission electronic micrograph of S. aureus treated with DMF illustrating decreased size of cocci cells, electron dense boundary cell wall increased in thickness, numerous ribosomes (single asterisks), electron dense granules (double asterisks) and increased number of cells forming division septa. (Specimen fixed in 4F1G solution and double-stained with uranyl acetate and lead citrate; original magnification ×7500)
Transmission electronic micrograph of S. aureus treated with ligand (HL8) illustrating cocci cells, electron lucent or damaged boundary cell wall, numerous ribosomes (single asterisks), electron dense granules (double asterisks), granular cell contents appear to be exuding from the damaged membrane (triple asterisks), vacuoles of electron lucent regions are formed in the cytoplasm (four asterisks). (Specimen fixed in 4F1G solution and double-stained with uranyl acetate and lead citrate; original magnification ×7500)
Transmission electronic micrograph of normal E. coli showing rod shaped cells, normal smooth continuous cell wall and cell membrane, homogenous electron dense cytoplasm, normal electron lucent region between cell wall and cell membrane and normal cell division (single asterisks). (Specimen fixed in 4F1G solution and double stained with uranyl acetate and lead citrate; original magnification ×7500)
Transmission electronic micrograph of E. coli treated with DMF showing rod shaped cells, normal smooth continuous cell wall and cell membrane, homogenous electron dense cytoplasm and normal electron lucent region between cell wall and cell membrane. (Specimen fixed in 4F1G solution and double-stained with uranyl acetate and lead citrate; original magnification ×7500)
Transmission electronic micrograph of E. coli treated with ligand (HL8) showing malformed cells with rough irregular cell wall, granular cell contents appear to be exuding from the damaged membrane (single asterisks) and vacuoles of electron lucent regions are formed in the cytoplasm (double asterisks, four asterisks). (Specimen fixed in 4F1G solution and double-stained with uranyl acetate and lead citrate; original magnification ×7500)
Conclusion
Azo ligands (HL n ) (where n = 1–5), azo Schiff base ligands (HL n ) (where n = 6–10) were synthesized and characterized by elemental analysis, IR, 1H NMR, X-ray diffraction analysis, mass spectra and thermal studies. The azo quinoline ligands [5-(4′-derivatives phenyldiazo)-8-hydroxy-7-quinolinecarboxaldehyde[ HL1–5 are a mixture of amorphous and polycrystalline structures while azo Schiff base ligands 4-{[5-(4-substituted-phenylazo)-8-hydroxy-quinolin-7-ylmethylene]-amino}-1,5-dimethyl-2-phenyl-1,2-dihydro-pyrazol-3-one derivatives HL6–10 are completely amorphous. The molecular ion peaks of HL2 and (HL6, HL8 and HL9) are in good agreement with their suggested empirical formulae as indicated from elemental analyses. The variation of azo and azomethine groups strongly affected the decomposition behavior and the values of thermal activation energy E d of decomposition. The antimicrobial activity was tested against B. cereus, S. aureus, E. coli, K. pneumoniae, A. niger, F. oxysporum, A. alternata and P. italicum. The antimicrobial tests proved that none of the used azo compounds have any antimicrobial activity, while both tested azo Schiff base compounds have antibacterial activity on E. coli and K. pneumoniae and antifungal activity on A. alternata, A. niger and P. italicum. Ultrastructure study of affected E. coli and S. aureus confirmed that HL8 has antibacterial activity.
References
H. Zollinger, Color Chemistry (VCH, Weinheim, 1991)
K.T. Chung, C.E. Cerniglia, Mutat. Res. 277, 201–220 (1992)
K.T. Chung, S.E.J. Stevens, Environ. Toxicol. Chem. 12, 2121–2132 (1993)
P.K. Wong, P.Y. Yuen, Water Res. 30, 1736–1744 (1996)
D.N. Dhar, C.L. Taploo, J. Sci. Ind. Res. 41, 501–506 (1982)
P. Przybylski, A. Huczynski, K. Pyta, B. Brzezinski, F. Bartl, Curr. Org. Chem. 13, 124–148 (2009)
C.M. da Silva, D.L. da Silva, L.V. Modolo, R.B. Alves, M.A. de Resende, C.V.B. Martins, Â. de Fátima, J. Adv. Res. 2, 1–8 (2011)
K.I. Bhat, R.V. Kumar, B. Kalluraya, Asian J. Chem. 16, 96–102 (2004)
G.K. Rao, R. Kaur, P.N.S. Pai, Der Pharm. Chem. 3, 323–329 (2011)
A.A. Jarrahpour, M. Motamedifar, K. Pakshir, N. Hadi, M. Zarei, Molecules 9, 815–824 (2004)
M. Zarei, A. Jarrahpour, Iran. J. Sci. Technol. A3, 235–242 (2011)
S. Eswaran, A.V. Adhikari, N.S. Shetty, Eur. J. Med. Chem. 44, 4637–4647 (2009)
C. Caris, P. Baret, J.L. Pierre, G. Serratrice, Tetrahedron 52, 4659–4672 (1996)
K.H. Lam, R. Gambari, K.K.H. Lee, Y.X. Chen, S.H.L. Kok, R.S.M. Wong, F.Y. Lau, C.H. Cheng, W.Y. Wong, Z.X. Bian, A.S.C. Chan, J.C.O. Tang, C.H. Chui, Bioorg. Med. Chem. Lett. 24, 367–370 (2014)
M. El-Behery, H. El-Twigry, Spectrochim. Acta A 66, 28–36 (2007)
M.I. Abou-Dobara, M.A. Diab, A.Z. El-Sonbati, A.M. Barakat, Arab. J. Chem. (2013). doi:10.1016/j.arabjc.2013.03.018
A.Z. El-Sonbati, A.A. El-bindary, A.F. Shoair, R.M. Younes, Chem. Pharm. Bull. 49, 1308–1313 (2001)
A.Z. El-Sonbati, A.A. El-bindary, Polish J. Chem. 74, 621–630 (2000)
N.A. El-Ghamaz, M.A. Diab, A.A. El-Bindary, A.Z. El-Sonbati, S.G. Nozha, Spectrochim. Acta A 143, 200–212 (2015)
M.M. El-Nahass, H.S. Soliman, N. El-Kadry, A.Y. Morsy, S. Yaghmour, J. Mater. Sci. Lett. 7, 1050–1053 (1988)
N.A. El-Ghamaz, M.A. Diab, A.A. El-Bindary, A.Z. El-Sonbati, S.G. Nozha, Solid State Sci. 30, 44–54 (2014)
M.A. Diab, A.Z. El-Sonbati, A.A. El-Bindary, A.M. Barakat, Spectrochim. Acta A 116, 428–439 (2013)
M.A. Diab, A.A. El-Bindary, A.Z. El-Sonbait, O.L. Salem, J. Mol. Struct. 1018, 176–184 (2012)
N.A. El-Ghamaz, M.A. Diab, A.Z. El-Sonbati, O.L. Salem, Spectrochim. Acta A 83, 61–66 (2011)
M.I. Abou-Dobara, A.Z. El-Sonbati, ShM Morgan, World J. Microbiol. Biotech. 29, 119–126 (2013)
A.Z. El-Sonbati, A.A.M. Belal, M.S. El-Gharib, ShM Morgan, Spectrochim. Acta A 95, 627–636 (2012)
A.W. Coats, J.P. Redfern, Nature 20, 68–79 (1964)
H.W. Horowitz, G. Metzger, Anal. Chem. 35, 1464–1468 (1963)
A.Z. El-Sonbati, M.A. Diab, A.A. El-Bindary, A.M. Eldesoky, ShM Morgan, Spectrochim. Acta A 135, 774–791 (2015)
M.M. Ghoneim, A.Z. El-Sonbati, A.A. El-Bindary, M.A. Diab, L.S. Serag, Spectrochim. Acta A 140, 111–131 (2015)
E.W. Koneman, Koneman’s Color Atlas and Textbook of Diagnostic Microbiology, 2006
B. Forbes, Bailey and Scott’s Diagnostic Microbiology - Elsevier eBook on VitalSource, 12th Edn, 2002
A.U. Patel, E-J. Chem. 6, 1247–1252 (2009)
G. Neumann, Y. Veeranagouda, T.B. Karegoudar, O. Sahin, I. Mausezahl, N. Kabelitz, U. Kappelmeyer, H.J. Heipieper, Extremophiles 9, 163–168 (2005)
G.W. O’Hara, A.R. Glenn, Arch. Microbiol. 161, 286–292 (1994)
M. Ritz, J.L. Tholozan, M. Federighi, M.F. Pilet, Appl. Environ. Microbiol. 67, 2240–2247 (2001)
M.I. Abou-Dobara, A.Z. El-Sonbati, M.A. Diab, A.A. El-Bindary, ShM Morgan, J. Microbial. Biochem. Technol. (2014). doi:10.4172/1948-5948.S3-006
Acknowledgments
The authors would like to thank Prof. Dr. Nabila El-Sayed Abdel Meguid Prof. Emeritus of Cytology and Cytochemistry, Zoology Department, Faculty of Science, Alexandria University, Egypt and Miss N.F. Omar, Botany Department, Faculty of Science, Damietta University, Egypt for their help during testing antimicrobial activities and ultrastructure study.
Author information
Authors and Affiliations
Corresponding author
Ethics declarations
Ethical statement
On behalf of the authors of our paper entitled “Dielectrical properties and conduction mechanism of quinoline Schiff base and its complexes”, we certify that this paper is abstracted from our own work. This work is carried out in our laboratory and the obtained results have not been published in any journals. We have not received any grant from any agencies or company. We state that we do not have any conflict of interest with anyone.
Additional information
S. G. Nozha: Abstracted from her Ph.D. Thesis.
Rights and permissions
About this article
Cite this article
El-Sonbati, A.Z., Abou-Dobara, M.I., Diab, M.A. et al. Synthesis, characterization, antimicrobial activity and ultrastructure of the affected bacteria of new quinoline compounds. Res Chem Intermed 42, 6449–6481 (2016). https://doi.org/10.1007/s11164-016-2474-2
Received:
Accepted:
Published:
Issue Date:
DOI: https://doi.org/10.1007/s11164-016-2474-2